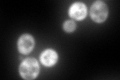
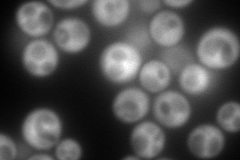
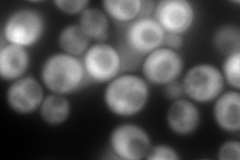
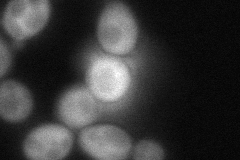
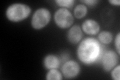

View description
P-loop ATPase with similarity to human OLA1 and bacterial YchF; identified as specifically interacting with the proteasome; protein levels are induced by hydrogen peroxide
Localization:
Intensity:
Fold change:
Significance:
-
C’ GFP library in SD
cytosol275.24 -
N' NOP1pr-GFP in SD
cytosol426.469 -
N' TEF2pr-mCherry in SD
cytosol527.962 -
N' NATIVEpr-GFP in SD

cytosol229.65 -
N' TEF2pr-VC and Cyto-VN in SD
cytosol91.9151 -
C’ GFP library in SD+DTT

cytosol393.051.42No -
C’ GFP library in SD+H2O2

cytosol388.571.41No -
C’ GFP library in Starvation Media
cytosol609.782.21Yes -
C’ GFP library on the background of Pup2-DaMP

N/A -
C’ GFP library on the background of CCT mutant

N/A0N/AYes
